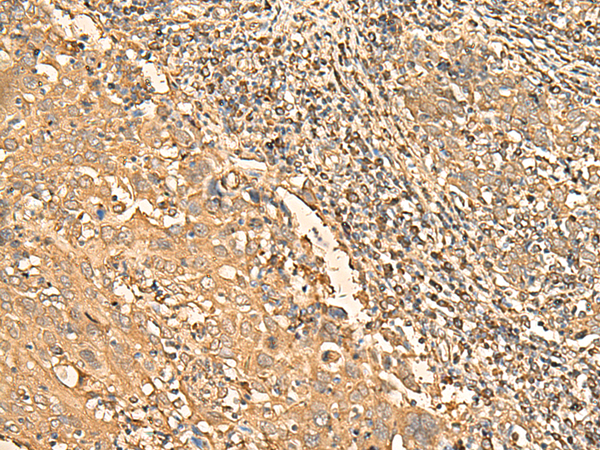

中文名稱: 兔抗RPS28多克隆抗體
英文名稱: Anti-RPS28 rabbit polyclonal antibody
別 名: ribosomal protein S28; S28; DBA15
儲 存: 冷凍(-20℃)
抗 原: RPS28
宿 主: Rabbit
反應(yīng)種屬: Human, Mouse, Rat
相關(guān)類別: 一抗
標(biāo) 記 物: Unconjugate
克隆類型: rabbit polyclonal
技術(shù)規(guī)格
Background:
Ribosomes, the organelles that catalyze protein synthesis, consist of a small 40S subunit and a large 60S subunit. Together these subunits are composed of 4 RNA species and approximately 80 structurally distinct proteins. This gene encodes a ribosomal protein that is a component of the 40S subunit. The protein belongs to the S28E family of ribosomal proteins. It is located in the cytoplasm. As is typical for genes encoding ribosomal proteins, there are multiple processed pseudogenes of this gene dispersed through the genome.
Applications:
ELISA, WB, IHC
Name of antibody:
RPS28
Immunogen:
Synthetic peptide of human RPS28
Full name:
ribosomal protein S28
Synonyms:
S28; DBA15
SwissProt:
P62857
ELISA Recommended dilution:
5000-10000
IHC positive control:
Human cervical cancer and Human colorectal cancer
IHC Recommend dilution:
40-200
WB Predicted band size:
8 kDa
WB Positive control:
293T and PC3 cell, Mouse spleen tissue, 231 cell, Human breast cancer tissue, Mouse kidney tissue lysates
WB Recommended dilution:
500-2000

購物車
幫助
021-54845833/15800441009
